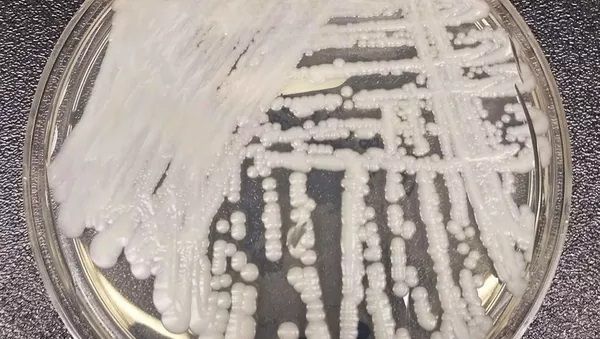
Content image

マスクの装着に制限がなくなり、新型コロナウィルスも少しずつと過去のものになってきたように感じます。
人によっては誰かと会うときはマスクをしていた方が楽という場合もあったかもしれませんが、今後はそれも個人の自由となるようですね。
そんな感染症に対しては落ち着きを取り戻した日本ですが、世界的にはコロナ禍で息を潜めていたある感染症が問題になっています。
その名はカンジダ・アウリス。
もしかしたら今後日本国内で耳にする新たな病気の一つになるかもしれません。
参考記事)
・New Deadly Superfungus Can Now Be Found in Half of US States
・General Information about Candida auris
・Candida auris: what you need to know about the deadly fungus spreading through US hospitals
・東洋経済オンライン人殺し「耐性カンジダ菌」世界同時発生の恐怖

2005年に東京で発見され、2009年に新種記載された酵母です。
パンデミックを起こした初めての真菌でもあります。
現在までで4つの株に変異しており、日本で発見された株(東アジア型)は大きな病原性を示していません。
一方、南アジア型、南アフリカ型、南アメリカ型の株は、遺伝子の変異によって様々な耐性がついたことによって、パンデミックが引き起こされています。
耳漏患者の組織から見つかり、2009〜2013年にインドにてアウトブレーク、2012年に南アフリカ共和国およびベネズエラにて、2013、2015、2016年には英国にて、2016年には中国でアウトブレークが、起こっており、世界的な流行化を見せています。
※アウトブレーク=限定された領域(国、村、病院内など)の中で、一定期間に予想以上の頻度で疾病が発生すること
他のカンジダ種と異なるのは、腸内ではなく皮膚に定着して成長、増殖すること、そして長期生存が可能なことです。
これにより、病院や介護施設など、ベッドやシーツが真菌で汚染され、完全な除去が困難だという点もアウトブレークに繋がっています。
現在米国では、2019年から2021年の間に3倍もの感染増加が確認されています。
カンジダ・アウリスの大きな問題点は、薬剤に対する耐性がつきやすいということです。
消毒薬に対しても耐性があるため、塩化ベンザルコニウム(逆性石鹸)などで消毒をすると、在来菌を殺してカンジダ・アウリスが残るといった状態もあります。
カンジダ・アウリスが定着している多くの人は、それで病気になることはなく、そのことにする、気づきません。
手術の傷や、何らかのきっかけで血液の中に入ると感染を引き起こします。
体内に入ると、血液から臓器など全身に感染し、深刻で致命的な病気を引き起こす可能性があります!
致死率は概ね30〜60%とされていますが、他の病気と併発している場合のデータであるため、正確な死亡率を特定できてはいません。
感染すると、発熱、悪寒、吐き気など症状は多岐にわたり、感染症の診断が困難な場合も多く注意深く観察する必要があります。
また、新型コロナウィルスの流行も部分的に関係していると考えられています。
COVIDで重篤化した患者は、ICUでの長期滞在が必要になる場合があり、そういった環境がカンジダ・アウリスのコロニーの形成や感染拡大の危険因子とされています。
パンデミックが世界中の真菌感染症の発生率と数にどのように影響したかを正確に把握するには、まだ時間が必要です。
しかし、英国が感染拡大を防いだ例もあるため、この感染症の症例がどのように変動するかを注意深く予測し、警戒していく必要がありそうです。
・カンジダ・アウリスは致死性のある病原菌
・遺伝子の変化によって、薬剤耐性がついているものも現れている
・人の皮膚の上で長期生存が可能
・世界的なパンデミックになりつつある(もうなっている)
国際的には重大なトピックとなっていますが、日本においては大きな問題になっていないことから認知度は低いです。
今後、カンジダ・アウリス名をを日本で聞くことがあったら、それは遺伝子変異した病原菌が広まっていく合図なのかもしれません。
人間の皮膚で長期生存可能な菌でもあるので、手洗いうがいを含め、寝具などのケアも一層の注意が必要になっていくかもしれません。










